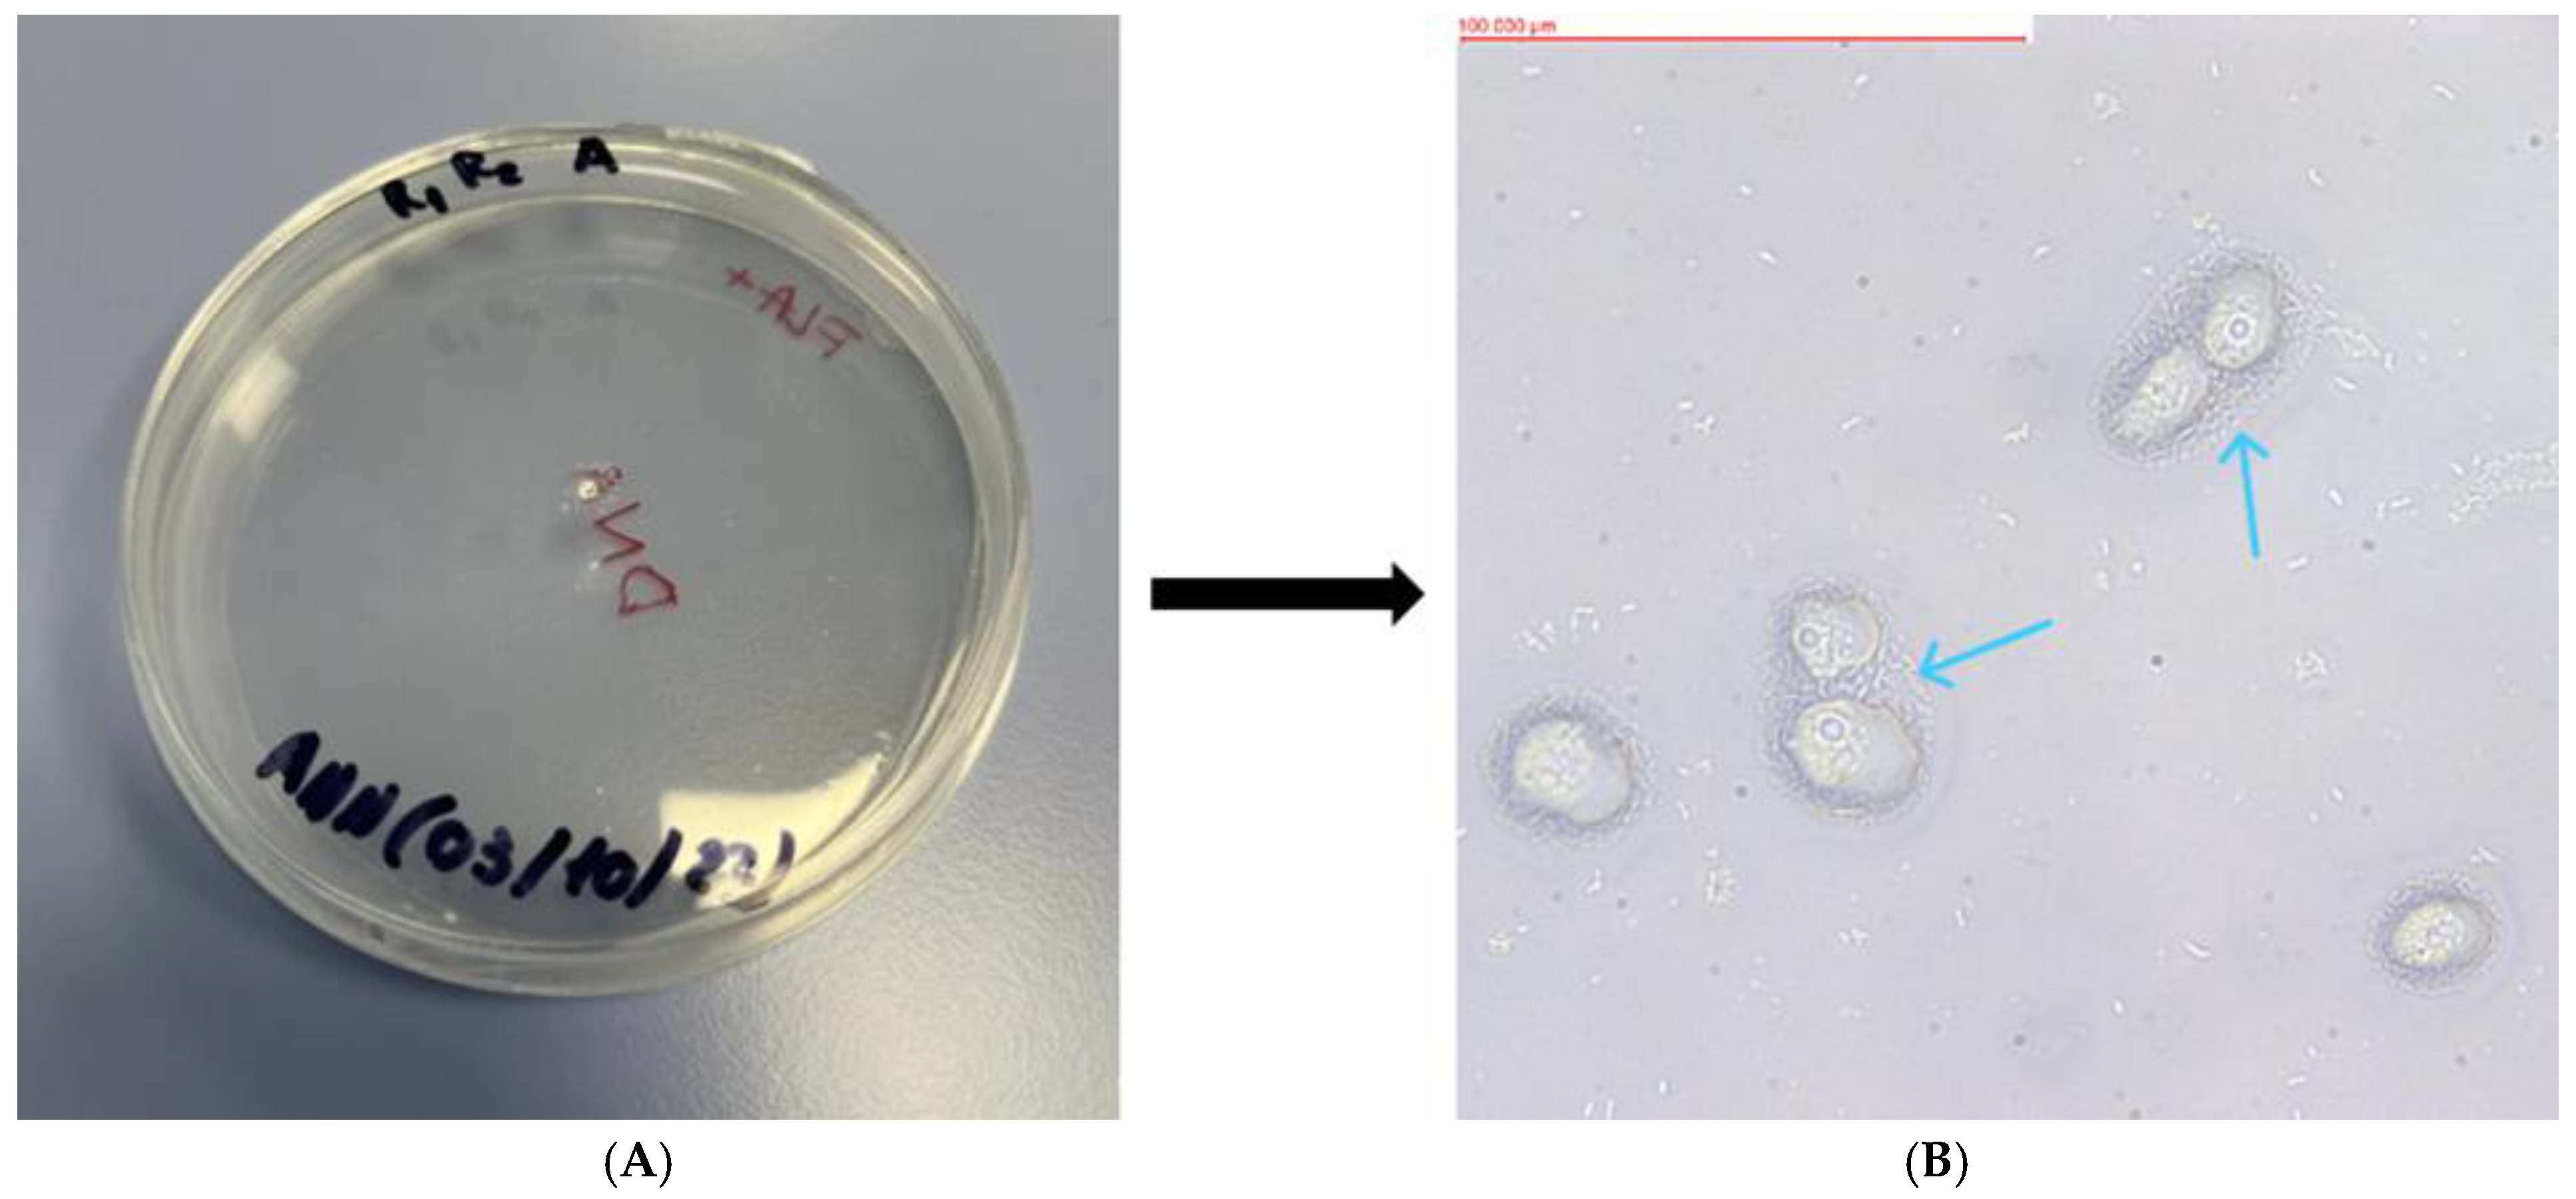
Pathogens 13 00895 g002

Potentially Pathogenic Free-Living Amoebae Isolated from Soil Samples from Warsaw Parks and Squares
Abstract
1. Introduction
2. Materials and Methods
2.1. Sampling Site
- Zaslaw Malicki Park (WAWA)
- Szczęśliwicki Park (WAWB)
- Olszyna Park (WAWC)
- Kaskada Park (WAWD)
- Krasiński Garden (WAWE)
- Saski Garden (WAWF)
- Świętokrzyski Park (WAWG)
- Arkadia Park (WAWH)
- Park named after the Home Army ‘Granat’ Group (WAWI)
- Pola Mokotowskie (2 samples) (WAWJ, WAWK)
- Royal Łazienki Park (2 samples) (WAWL, WAWM)
- Marshall Edward Rydz-Smigly Park (WAWN, WAWO)
- Stefan Wiechecki “Wiecha” Park (WAWP)
- Praski Park (WAWR)
- Skaryszewski Park (3 samples) (WAWS, WAWT, WAWU)
- Edward Szymański Park (WAWW, WAWX)
- Górczewska Park (WAWY)
2.2. FLA Culture
2.3. Thermophilicity
2.4. DNA Extraction
2.5. PCR and Molecular Characterisation of Isolates
2.6. Phylogenetic Analysis
3. Results
3.1. FLA Culture
3.2. Thermophilicity
3.3. Molecular Characterisation of Isolates
4. Discussion
5. Conclusions
Author Contributions
Funding
Institutional Review Board Statement
Informed Consent Statement
Data Availability Statement
Conflicts of Interest
References
- Visvesvara, G.S.; Moura, H.; Schuster, F.L. Pathogenic and opportunistic free-living amoebae: Acanthamoeba spp., Balamuthia mandrillaris, Naegleria fowleri, and Sappinia diploidea. FEMS Immunol. Med. Microbiol. 2007, 50, 1–26. [Google Scholar] [CrossRef] [PubMed]
- Reyes-Batlle, M.; Todd, C.D.; Martín-Navarro, C.M.; López-Arencibia, A.; Cabello-Vilchez, A.M.; González, A.C.; Córdoba-Lanús, E.; Lindo, J.F.; Valladares, B.; Piñero, J.E.; et al. Isolation and characterization of Acanthamoeba strains from soil samples in Gran Canaria, Canary Islands, Spain. Parasitol. Res. 2014, 113, 1383–1388. [Google Scholar] [CrossRef] [PubMed]
- Mahmoudi, M.R.; Maleki, M.; Zebardast, N.; Rahmati, B.; Ashrafi, K.; Sharifdini, M.; Karanis, P. Identification of Acanthamoeba spp. from water and soil of public parks in the north of Iran. J. Water Health 2022, 20, 1604–1610. [Google Scholar] [CrossRef] [PubMed]
- Barnhart, E.P.; Kinsey, S.M.; Wright, P.R.; Caldwell, S.L.; Hill, V.; Kahler, A.; Mattioli, M.; Cornman, R.S.; Iwanowicz, D.; Eddy, Z.; et al. Naegleria fowleri Detected in Grand Teton National Park Hot Springs. ACS ES T Water. 2024, 4, 628–637. [Google Scholar] [CrossRef] [PubMed] [PubMed Central]
- Ghaderifar, S.; Najafpoor, A.A.; Zarrinfar, H.; Esmaily, H.; Hajialilo, E. Isolation and identification of Acanthamoeba from pond water of parks in a tropical and subtropical region in the Middle East, and its relation with physicochemical parameters. BMC Microbiol. 2018, 18, 139. [Google Scholar] [CrossRef] [PubMed] [PubMed Central]
- Abedi, B.; Azadi, D.; Hajihossein, R.; Khodashenas, S.; Ghaffari, K.; Mosayebi, M. Isolation and molecular identification of Acanthamoeba spp. from hospital dust and soil of Khomein, Iran, as reservoir for nosocomial infection. Parasite Epidemiol. Control. 2021, 15, e00224. [Google Scholar] [CrossRef] [PubMed] [PubMed Central]
- Gabr, N.S.; Mohamed, R.M.; Belal, U.S.; Abdel-Fatah, M.M.; Ahmed, R.F.; Abdel Gaber, N.A.T.; Abdel-Hafeez, E.H. Isolation and Identification of Pathogenic Acanthamoeba Species from Air Conditioning Systems, Egypt. Jpn. J. Infect. Dis. 2021, 74, 180–186. [Google Scholar] [CrossRef] [PubMed]
- Trabelsi, H.; Dendana, F.; Sellami, A.; Sellami, H.; Cheikhrouhou, F.; Neji, S.; Makni, F.; Ayadi, A. Pathogenic free-living amoebae: Epidemiology and clinical review. Pathol. Biol. 2012, 60, 399–405. [Google Scholar] [CrossRef] [PubMed]
- Adl, S.M.; Simpson, A.G.B.; Farmer, M.A.; Andersen, R.A.; Anderson, O.R.; Barta, J.R.; Bowser, S.S.; Brugerolle, G.; Fensome, R.A.; Fredericq, S.; et al. The new higher-level classification of eukaryotes with emphasis on the taxonomy of protists. J. Eukaryot. Microbiol. 2005, 52, 399–451. [Google Scholar] [CrossRef]
- Sousa-Ramos, D.; Reyes-Batlle, M.; Bellini, N.K.; Rodríguez-Expósito, R.L.; Piñero, J.E.; Lorenzo-Morales, J. Free-Living Amoebae in Soil Samples from Santiago Island, Cape Verde. Microorganisms 2021, 9, 1460. [Google Scholar] [CrossRef] [PubMed] [PubMed Central]
- Król-Turmińska, K.; Olender, A. Human infections caused by free-living amoebae. Ann. Agric. Environ. Med. 2017, 24, 254–260. [Google Scholar] [CrossRef] [PubMed]
- Winiecka-Krusnell, J.; Linder, E. Free-living amoebae protecting Legionella in water: The tip of an iceberg? Scand. J. Infect. Dis. 1999, 31, 383–385. [Google Scholar] [CrossRef] [PubMed]
- Wheat, W.H.; Casali, A.L.; Thomas, V.; Spencer, J.S.; Lahiri, R.; Williams, D.L.; McDonnell, G.E.; Gonzalez-Juarrero, M.; Brennan, P.J.; Jackson, M. Long-term survival and virulence of Mycobacterium leprae in amoebal cysts. PLoS Negl. Trop. Dis. 2014, 8, e3405. [Google Scholar] [CrossRef] [PubMed] [PubMed Central]
- Denet, E.; Coupat-Goutaland, B.; Nazaret, S.; Pélandakis, M.; Favre-Bonté, S. Diversity of free-living amoebae in soils and their associated human opportunistic bacteria. Parasitol. Res. 2017, 116, 3151–3162. [Google Scholar] [CrossRef] [PubMed]
- Statistical Review of Warsaw—Quarter 3/2023; Statistical Office: Warsaw, Poland, 2023; Volume 32.
- Potencjał do Kształtowania Warunków Klimatycznych—W tym Wymiany i Regeneracji Powietrza w Warszawie, Raport Przygotował Zespół: ATMOTERM S.A., ATMOTERM Inżynieria Środowiska Sp. z o.o., Instytut Meteorologii i Gospodarki Wodnej, Politechnika Warszawska, Pracownia Urbanistyki KANON. 2017.
- Tsyganov, A.N.; Nijs, I.; Beyens, L. Does climate warming stimulate or inhibit soil protist communities? A test on testate amoebae in high-arctic tundra with free-air temperature increase. Protist 2011, 162, 237–248. [Google Scholar] [CrossRef] [PubMed]
- Tsvetkova, N.; Schild, M.; Panaiotov, S.; Kurdova-Mintcheva, R.; Gottstein, B.; Walochnik, J.; Aspöck, H.; Lucas, M.S.; Müller, N. The identification of free-living environmental isolates of amoebae from Bulgaria. Parasitol. Res. 2004, 92, 405–413. [Google Scholar] [CrossRef] [PubMed]
- Schroeder, J.M.; Booton, G.C.; Hay, J.; Niszl, I.A.; Seal, D.V.; Markus, M.B.; Fuerst, P.A.; Byers, T.J. Use of subgenic 18S ribosomal DNA PCR and sequencing for genus and genotype identification of acanthamoebae from humans with keratitis and from sewage sludge. J. Clin. Microbiol. 2001, 39, 1903–1911. [Google Scholar] [CrossRef] [PubMed] [PubMed Central]
- Dereeper, A.; Guignon, V.; Blanc, G.; Audic, S.; Buffet, S.; Chevenet, F.; Dufayard, J.F.; Guindon, S.; Lefort, V.; Lescot, M.; et al. Phylogeny.fr: Robust phylogenetic analysis for the non-specialist. Nucleic Acids Res. 2008, 36, W465–W469. [Google Scholar] [CrossRef] [PubMed] [PubMed Central]
- Edgar, R.C. MUSCLE: Multiple sequence alignment with high accuracy and high throughput. Nucleic Acids Res. 2004, 32, 1792–1797. [Google Scholar] [CrossRef]
- Castresana, J. Selection of conserved blocks from multiple alignments for their use in phylogenetic analysis. Mol. Biol. Evol. 2000, 17, 540–552. [Google Scholar] [CrossRef]
- Anisimova, M.; Gascuel, O. Approximate likelihood ratio test for branchs: A fast, accurate and powerful alternative. Syst. Biol. 2006, 55, 539–552. [Google Scholar] [CrossRef] [PubMed]
- Guindon, S.; Gascuel, O. A simple, fast, and accurate algorithm to estimate large phylogenies by maximum likelihood. Syst. Biol. 2003, 52, 696–704. [Google Scholar] [CrossRef] [PubMed]
- Chevenet, F.; Brun, C.; Banuls, A.L.; Jacq, B.; Chisten, R. TreeDyn: Towards dynamic graphics and annotations for analyses of trees. BMC Bioinform. 2006, 10, 439. [Google Scholar] [CrossRef] [PubMed]
- Derda, M.; Solarczyk, P.; Cholewiński, M.; Hadaś, E. Genotypic characterization of amoeba isolated from Acanthamoeba keratitis in Poland. Parasitol. Res. 2015, 114, 1233–1237. [Google Scholar] [CrossRef] [PubMed] [PubMed Central]
- Daas, L.; Szentmáry, N.; Eppig, T.; Langenbucher, A.; Hasenfus, A.; Roth, M.; Saeger, M.; Nölle, B.; Lippmann, B.; Böhringer, D.; et al. Das Deutsche Akanthamöbenkeratitis-Register: Erste Ergebnisse einer multizentrischen Erhebung [The German Acanthamoeba keratitis register: Initial results of a multicenter study]. Der Ophthalmol. 2015, 112, 752–763. Erratum in Der Ophthalmol. 2015, 112, 942(In German) [Google Scholar] [CrossRef] [PubMed]
- Orosz, E.; Kriskó, D.; Shi, L.; Sándor, G.L.; Kiss, H.J.; Seitz, B.; Nagy, Z.Z.; Szentmáry, N. Clinical course of Acanthamoeba keratitis by genotypes T4 and T8 in Hungary. Acta Microbiol. Et Immunol. Hung. 2019, 66, 289–300. [Google Scholar] [CrossRef] [PubMed]
- Cholewinski, M.; Solarczyk, P.; Derda, M.; Wojtkowiak-Giera, A.; Hadas, E. Presence of potential pathogenic genotypes of free-living amoebae isolated from sandboxes in children’s playgrounds. Folia Parasitol. 2015, 62, 064. [Google Scholar] [CrossRef] [PubMed]
- Adamska, M.; Leonska-Duniec, A.; Lanocha, N.; Skotarczak, B. Thermophilic potentially pathogenic amoebae isolated from natural water bodies in Poland and their molecular characterization. Acta Parasitol. 2014, 59, 433–441. [Google Scholar] [CrossRef] [PubMed]
- Leońska-Duniec, A.; Skotarczak, B.; Adamska, M. Molecular identification of free-living amoebae isolated from artificial water bodies located in Poland. Acta Protozool. 2015, 54, 77–84. [Google Scholar]
- Cholewiński, M.; Hadas, E.; Derda, M.; Wojt, W.; Skrzypczak, Ł. Występowanie patogenicznych pełzaków wolno żyjących z rodzaju Acanthamoeba w piaskownicach miejskich (The occurrence of the pathogenic free-living amoeba from Acanthamoeba genus in city’s sandboxes). Now. Lek. 2013, 82, 138–141. [Google Scholar]
- Maciver, S.K.; Asif, M.; Simmen, M.W.; Lorenzo-Morales, J. A systematic analysis of Acanthamoeba genotype frequency correlated with source and pathogenicity: T4 is confirmed as a pathogen-rich genotype. Eur. J. Protistol. 2013, 49, 217–221. [Google Scholar] [CrossRef] [PubMed]
- Lorenzo-Morales, J.; Khan, N.A.; Walochnik, J. An update on Acanthamoeba keratitis: 75 diagnosis, pathogenesis and treatment. Parasite 2015, 22, 10. [Google Scholar] [CrossRef] [PubMed]
- Grimm, D.; Ludwig, W.F.; Brandt, B.C.; Michel, R.; Schleifer, K.H.; Hacker, J.; Steinert, M. Development of 18S rRNA-targeted oligonucleotide probes for specific detection of Hartmannella and Naegleria in Legionella-positive environmental samples. Syst. Appl. Microbiol. 2001, 24, 76–82. [Google Scholar] [CrossRef] [PubMed]
- Tolba, M.E.; Huseein, E.A.; Farrag, H.M.; Mohamed Hel, D.; Kobayashi, S.; Suzuki, J.; Ali, T.A.; Sugano, S. Allovahlkampfia spelaea Causing Keratitis in Humans. PLoS Negl. Trop. Dis. 2016, 10, e0004841. [Google Scholar] [CrossRef] [PubMed] [PubMed Central]
- Nageeb, M.M.; Eldeek, H.E.M.; Attia, R.A.H.; Sakla, A.A.; Alkhalil, S.S.; Farrag, H.M.M. Isolation and morphological and molecular characterization of waterborne free-living amoebae: Evidence of potentially pathogenic Acanthamoeba and Vahlkampfiidae in Assiut, Upper Egypt. PLoS ONE. 2022, 17, e0267591. [Google Scholar] [CrossRef] [PubMed] [PubMed Central]
- Stockman, L.J.; Wright, C.J.; Visvesvara, G.S.; Fields, B.S.; Beach, M.J. Prevalence of Acanthamoeba spp. and other free-living amoebae in household water, Ohio, USA—1990–1992. Parasitol. Res. 2011, 108, 621–627. [Google Scholar] [CrossRef]

| Name | 5′-3′ Sequence | Tm [°C] | Amplicon Length [bp] | Source |
|---|---|---|---|---|
| FLA-F | CGCGGTAATTCCAGCTCCAATAGC | 55 | ~800 | [18] |
| FLA-R | CAGGTTAAGGTCTCGTTCGTTAAC | |||
| JDP-1 | GGCCCAGATCGTTTACCGTGAA | 50 | ~500 | [19] |
| JDP-2 | TCTCACAAGCTGCTAGGGGAGTCA |
| Sample | Room Temperature | 37 °C | 45 °C | |||
|---|---|---|---|---|---|---|
| Before | After | Before | After | Before | After | |
| WAWA | T = 20 | T = 40 | T = 10 | T = 4 | T = 10 | T = 30 |
| - | - | - | C = 10 | - | - | |
| WAWC | . | T = 50 | T = 10 | . | T = 20 | . |
| - | C = 60 | - | - | - | - | |
| WAWE | T = 30 | T = 100 | T = 30 | T = 40 | T = 40 | T = 6 |
| - | - | - | C = 40 | - | C = 40 | |
| WAWF | T = 60 | T = 14 | T = 20 | - | T = 6 | T = 5 |
| C = 80 | C = 330 | C = 240 | C = 240 | C = 350 | C = 260 | |
| WAWG | T = 30 | T = 20 | T = 20 | T = 40 | T = 20 | T = 30 |
| C = 40 | C = 20 | C = 40 | C = 40 | C = 30 | C = 20 | |
| WAWI | T = 260 | T = 160 | T = 70 | T = 40 | T = 6 | T = 140 |
| C = 30 | - | - | C = 10 | C = 40 | C = 70 | |
| WAWK | . | T = 80 | . | . | . | . |
| - | C = 50 | - | . | . | . | |
| WAWL | T = 150 | T = 6 | T = 10 | T = 20 | T = 8 | T = 30 |
| C = 170 | C = 220 | C = 150 | C = 210 | C = 90 | C = 140 | |
| WAWM | T = 1 | T = 20 | - | - | - | - |
| C = 40 | C = 120 | C = 20 | C = 70 | C = 20 | C = 20 | |
| WAWN | ND | |||||
| WAWO | T = 30 | T = 40 | T = 20 | - | T = 30 | - |
| C = 9 | C = 40 | C = 8 | C = 100 | C = 30 | C = 110 | |
| WAWP | T = 10 | T = 10 | T = 5 | T = 20 | T = 10 | - |
| C = 80 | C = 170 | C = 90 | C = 150 | C = 200 | C = 50 | |
| WAWR | T = 20 | T = 30 | T = 15 | T = 20 | T = 20 | - |
| C = 90 | C = 190 | C = 20 | C = 230 | C = 100 | C = 20 | |
| WAWS | T = 9 | T = 40 | T = 10 | T = 8 | - | - |
| C = 1 | C = 40 | C = 40 | C = 20 | C = 80 | C = 60 | |
| WAWT | . | T = 100 | T = 50 | T = 20 | T = 40 | - |
| - | - | - | - | - | C = 3 | |
| WAWU | ND | |||||
| WAWW | T = 100 | T = 30 | T = 20 | T = 20 | T = 7 | - |
| C = 120 | C = 250 | C = 40 | C = 120 | C = 100 | C = 40 | |
| WAWY | T = 20 | T = 7 | T = 40 | T = 2 | T = 40 | - |
| C = 120 | C = 160 | C = 100 | C = 130 | C = 70 | C = 240 | |
| Sample Code | NNA | PCR Primers | Isolated Species | Seq Length (bp) | Identity (%) | ID BLASTn |
|---|---|---|---|---|---|---|
| WAWA | + | FLA | Platyamoeba placida | 850 | >95% | AY294150.1 |
| WAWC | + | JDP | Acanthamoeba sp. T4 | 426 | >98% | KP863877.1 |
| WAWE | + | FLA | Stenamoeba berchidia | 856 | >89% | KF547922.1 |
| WAWF | + | JDP | Acanthamoeba sp. T4 | 430 | >97% | OM414934.1 |
| WAWG | + | FLA | Platyamoeba placida | 842 | >97% | AY294150.1 |
| WAWI | + | JDP | Acanthamoeba sp. T4 | 416 | >89% | MT893156.1 |
| WAWK | + | JDP | Acanthamoeba sp. T4 | 416 | >99% | KP863877.1 |
| WAWL | + | FLA | Allovahlkampfia sp. | 837 | >98% | KF547914.1 |
| WAWM | + | JDP | Acanthamoeba sp. T4 | 426 | >99% | KJ094691.1 |
| WAWN | + | FLA | Platyamoeba placida | 844 | >97% | AY294150.1 |
| WAWO | + | JDP | Acanthamoeba sp. T4 | 420 | >95% | KP756958.1 |
| WAWP | + | JDP | Acanthamoeba sp. T4 | 424 | >98% | KJ094675.1 |
| WAWR | + | JDP | Acanthamoeba sp. T4 | 435 | >98% | LC373013.1 |
| WAWS | + | JDP | Acanthamoeba polyphaga | 409 | >98% | AY026244.1 |
| WAWT | + | JDP | Acanthamoeba sp. T4 | 426 | >99% | KJ094691.1 |
| WAWU | + | JDP | Acanthamoeba sp. T4 | 434 | >87% | OM414922.1 |
| WAWW | + | JDP | Acanthamoeba sp. T4 | 421 | >95% | OP164621.1 |
| WAWY | + | JDP | Acanthamoeba sp. T4 | 430 | >99% | KJ094675.1 |
Disclaimer/Publisher’s Note: The statements, opinions and data contained in all publications are solely those of the individual author(s) and contributor(s) and not of MDPI and/or the editor(s). MDPI and/or the editor(s) disclaim responsibility for any injury to people or property resulting from any ideas, methods, instructions or products referred to in the content. |
© 2024 by the authors. Licensee MDPI, Basel, Switzerland. This article is an open access article distributed under the terms and conditions of the Creative Commons Attribution (CC BY) license (https://creativecommons.org/licenses/by/4.0/).
Share and Cite
Hendiger-Rizo, E.B.; Chmielewska-Jeznach, M.; Poreda, K.; Rizo Liendo, A.; Koryszewska-Bagińska, A.; Olędzka, G.; Padzik, M. Potentially Pathogenic Free-Living Amoebae Isolated from Soil Samples from Warsaw Parks and Squares. Pathogens 2024, 13, 895. https://doi.org/10.3390/pathogens13100895
Hendiger-Rizo EB, Chmielewska-Jeznach M, Poreda K, Rizo Liendo A, Koryszewska-Bagińska A, Olędzka G, Padzik M. Potentially Pathogenic Free-Living Amoebae Isolated from Soil Samples from Warsaw Parks and Squares. Pathogens. 2024; 13(10):895. https://doi.org/10.3390/pathogens13100895
Chicago/Turabian StyleHendiger-Rizo, Edyta Beata, Magdalena Chmielewska-Jeznach, Katarzyna Poreda, Aitor Rizo Liendo, Anna Koryszewska-Bagińska, Gabriela Olędzka, and Marcin Padzik. 2024. "Potentially Pathogenic Free-Living Amoebae Isolated from Soil Samples from Warsaw Parks and Squares" Pathogens 13, no. 10: 895. https://doi.org/10.3390/pathogens13100895
APA StyleHendiger-Rizo, E. B., Chmielewska-Jeznach, M., Poreda, K., Rizo Liendo, A., Koryszewska-Bagińska, A., Olędzka, G., & Padzik, M. (2024). Potentially Pathogenic Free-Living Amoebae Isolated from Soil Samples from Warsaw Parks and Squares. Pathogens, 13(10), 895. https://doi.org/10.3390/pathogens13100895







